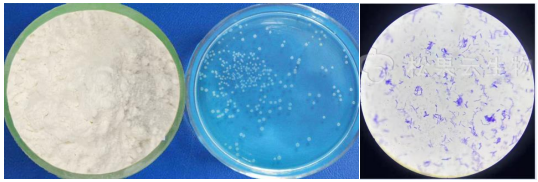

1. Introductions:
Enterococcus faecalis is a probiotic widely used in animal feed additive , medicine, and food industries.It is an anaerobic lactic acid bacteria,
2.Product Features
Appearance
Light Yellow White Powder
Odor
slight fermented flavor
Component
Enterococcus Faecalis and its metabolites,
suitable carriers
CAS
68607-31-0
Activities
1 Billion CFU/g, 10 Billion CFU/g, 20 Billion CFU/g, 100 Billion CFU/g,
Shelf life
12 Months ( Up to 24 months )
Widely Used In
Feed additive for fish, poultry and livestock.
For Fish, shrimp and aquatic products


Ms Wendy Lee
Mobile&Wechat&Whatsapp : 0086 13562692198
Email :yuedongbiotech@aliyun.com
Ms Jeff Wang
Mobile&Wechat&Whatsapp : 0086 13563622867
Email :wfyuedong@aliyun.com
Ms Sundy Lee
Mobile&Wechat&Whatsapp : 0086 15965090376
Email :yuedongsundy@aliyun.com


